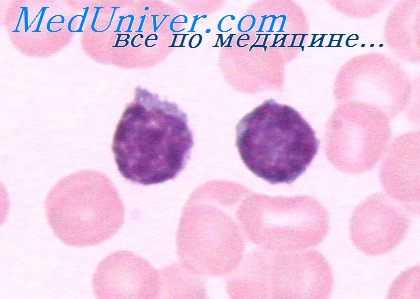
супрессорные лимфоциты

Ограничение синтеза антител. Исчерпание пролиферации антителообразующей клетки (АОК)
Добавил пользователь Дмитрий К. Обновлено: 04.11.2025
Ограничение синтеза антител. Исчерпание пролиферации антителообразующей клетки (АОК)
В начале статей по иммунологии были представлены данные, свидетельствующие о том, что благодаря экспоненциальному росту содержания антител и числа АОК их количество в течение нескольких дней после иммунизации могло бы превысить общее количество белков и клеток животного. Прекращение нарастания числа АОК и усиление биосинтеза антител могут быть обусловлены многими явлениями.
Мы остановимся лишь на некоторых:
1) исчерпание потенции пролиферации изучаемого клона АОК и исчерпание клеток-предшественников, необходимых для возникновения нового клона АОК;
2) исчерпание факторов, необходимых для пролиферации или вовлечения изучаемых АОК (выведение и разрушение антигена, исчерпание образования необходимых для пролиферации хелперных Т-клеток и т. д.);
3) появление факторов, активно тормозящих экспансию изучаемого клона.
Этими факторами могут быть антитела, образовавшиеся в первые дни после иммунизации, специфические или неспецифические ингибиторы, возникающие в организме в ответ на иммунизацию или пролиферацию образовавшегося клона, супрессорные Т- или В-клетки и т. д. Фаза снижения количества синтезируемых антител и числа АОК может явиться либо следствием естественной, невосполняемой гибели АОК, либо следствием активного процесса, приводящего к гибели АОК или к прекращению синтеза ими антител.
Ранее многие исследователи считали, что прекращение нарастания числа АОК после достижения пика антителообразования связано с исчерпанием их потенции к пролиферации благодаря тому, что АОК по мере дифференциации превращались в тупиковые, неспособные к делению зрелые плазматические клетки. Однако в настоящий момент вряд ли можно считать обоснованной такую точку зрения. Прежде всего против нее говорит то, что иногда в период максимального пика плазматические клетки составляют лишь 10% присутствующих АОК.

Еще более определенно против этой точки зрения говорят данные, полученные при последовательном переносе облученным мышам клеток селезенки, взятых первоначально от необлученной и иммунизированной сингенной мыши. Если мышам-реципиентам, помимо клеток, вводили антиген, то происходила интенсивная пролиферация клона АОК, образовавшегося в первичном необлученном доноре. При проведении таких опытов Виллиамсон и Асконас получили клон АОК, образующий антитела против ДНФ. Согласно их расчетам, клетки этого клона были способны к такому числу удвоений, в результате которого могло бы образоваться 10" клеток (Williamson, Askonas, 1972).
На чрезвычайно высокий пролиферативный потенциал указывают и аналогичные эксперименты, в которых в качестве антигена использовали эритроциты барана. Расчет показал, что при последовательных переносах каждый предшественник АОК способен совершить 38—40 делений, в результате которых мог бы образовать 1012 АОК.
Опыты по извлечению селезенок в эти периоды и культивированию их с антигеном вне организма указывают, что пролиферативный потенциал АОК не исчерпан не только в период максимального пика антителообразования, но и в период, когда антителообразование снижается. Было установлено, что вне организма число АОК быстро росло, а не уменьшалось, как это произошло бы, если бы селезенка осталась в ин-тактном организме. В результате этого за 3—4 дня число АОК в культурах во много превышало максимальное число АОК в интактном организме (10 000—60000 вместо 500—1000 АОК на 106 клеток селезенки) (Dutton, Mishell, 1967; Гурвич и др., 1974).
Описанный эффект нельзя объяснить тем, что на 4-й день после первичной иммунизации в организме мышей создается нехватка антигена, а к помещенным в культуры клеткам антиген добавляется вновь. Оказалось, что повторное введение интактным животным антигена через четыре дня после первичного приводит лишь к незначительному (в 1,5— 2,0 раза) увеличению числа АОК. Несколько большее влияние, но далеко не такое, как in vitro оказывает антиген, введенный на 7-й день после первичной иммунизации.
На основании приведенных выше данных можно сделать вывод, что прекращение нарастания синтеза антител и числа АОК и последующее их снижение не связано с исчерпанием пролиферативной способности клона или недостатком антигена. По-видимому, здесь мы сталкиваемся с действием факторов, активно тормозящих эти процессы. В пользу этой точки зрения говорит также и быстрота уменьшения числа АОК в период торможения антителообразования: их число за два дня иногда уменьшалось в 10 раз. Время жизни АОК, по некоторым данным (Klinman, Press, 1975), значительно больше.
Информация на сайте подлежит консультации лечащим врачом и не заменяет очной консультации с ним.
См. подробнее в пользовательском соглашении.
Супрессорные Т- и В-лимфоциты. Фаза торможения антителообразования
Хотя впервые супрессоры были обнаружены сравнительно недавно (Gershon, Kondo, 1970), их изучение продвинулось далеко.
Оказалось, что Т-супрессорные клетки играют существенную роль в развитии как клеточного, так и гуморального иммунитета. В частности, велика их роль в развитии ряда форм толерантности (Gershon, Kondo, 1970; Weigle e. a., 1975), и особенно толерантности малой дозы (Kolsch е. а., 1975). С их функцией, по-видимому, связана аллотипическая супрессия.
Накопление Т-супрессоров с возрастом обусловливает падение иммунной реактивности животных при старении (Segre, Segre, 1976), а уменьшение их содержания приводит к резкому усилению склонности к образованию аутоантител (Krakaur е. а., 1976).
Параллельно с изучением роли Т-супрессоров были разработаны методы их фракционирования (Dutton, 1975; Gerber, Steinberg, 1975), была показана их гетерогенность (например, наличие среди них короткоживущих и долгоживущих форм), различие локализации Т-супрессоров и Т-хелперов в органах (Baker, 1975).
Удалось показать, что действие Т-супрессоров осуществляется путем выделения медиаторов.
Т-супрессоры можно подразделить на две группы: антигенснецифические и антигеннеспецифическис. Так, после иммунизации мышей комплексом МСАБ — ГАТ (метилированный сывороточный альбумин быка — L-глютаминовая кислота 60, L-алапин 30, L-тирозин 10) образуются Т-супрессоры, ингибирующие развитие антителообразования к этому антигену, но не к эритроцитам барана (Benacerraf e. a., 1975).
Специфические Т-супрессоры выявлялись и после иммунизации другими антигенами (например, ДНФ, эритроциты барана или гамма-глобулин человека) (Doyle e. a., 1976; Weigle e. a., 1975). Однако в других условиях иммунизация этими же или сходными антигенами приводит к появлению неспецифических Т-супрессоров. К такому же результату может приводить действие митогепов (например, конканавалина А) (Dutton, 1975).
Механизм действия Т-супрессоров неясен. Они могут действовать либо прямо на В-клетки, либо опосредованно, например уменьшая число способствующих антителообразованию Т-клеток. Сейчас нет сомнения в том, что Т-супрессоры участвуют в подавлении антителообразования при многих иммунологических процессах. Менее ясно, в какой степени с действием Т-супрессоров связан перелом кривой антителообразования после достижения пика этого процесса.
В пользу значения Т-супрессоров в развитии этого феномена свидетельствуют следующие данные: 1) иммунизация приводит к увеличению числа этих клеток (причем это увеличение иногда происходит даже тогда, когда иммунизация не индуцирует антителообразование); 2) это увеличение можно выявить уже через трое суток после введения антигена (Benacerraf е. а., 1975).
Инъекция антилимфоцитарной сыворотки мышам, иммунизированным полисахаридом SSS III, снимает на некоторое время перелом кривой антителообразования. Приводятся аргументы в пользу того, что это связано с инактивирующим действием антисыворотки на Т-супрессоры (Baker, 1975). Тем не менее нет оснований считать вопрос решенным. Нарастание числа Т-супрессоров только начинается, когда наступает фаза торможения антителообразования.
Введение мышам специфических Т-супрессоров одновременно с их иммунизацией хотя и подавляет образование IgG AOK в дальнейшем, но мало влияет на максимальное количество образовавшихся IgM AOK.
И, наконец, мы пытались в прямых опытах проверить, действительно ли во время фазы торможения в селезенке накапливаются супрессорные клетки, тормозящие пролиферацию АОК. С этой целью клетки селезенки, извлеченные в период наиболее выраженного торможения антителообразования (через шесть дней после иммунизации мышей эритроцитами барана), добавляли in vitro к суспензии клеток селезенки (извлеченной через два дня после иммунизации), в которой уже заканчивалась индукция антителообразования и протекала активная пролиферация АОК. Добавление таких клеток не только не тормозило нарастание числа АОК, но даже несколько его стимулировало (на 151%) (Гурвич и др., 1974).
Для выяснения реального механизма торможения необходимы дальнейшие исследования.
Антигены лимфоидных органов. Распределение антигенов для дифференцировки АОК
На примере введения белковых антигенов может быть легко продемонстрирована гетерогенность территории лимфоузлов как плацдарма, на котором лимфоциты распознают антигены и дифференцируются в антителопродуцирующие клетки. Локализация меченных радиоизотопами антигенов характерным образом изменяется в лимфоузлах по срокам после их введения. После подкожного введения антиген накапливается в регионарных лимфоузлах. Уже через 5 мин он обнаруживается в макрофагах, выстилающих синусы мозгового слоя лимфоузла, а через 24 часа перемещается в корковый слой.
Здесь антиген располагается в ретикулярных клетках, лежащих на границе тимусзависимых и тимуснезависимых зон, а именно вблизи вторичных фолликулов. Содержащие антиген дендритические ретикулярные клетки имеют длинные цитоплазматические отростки, на наружной клеточной мембране которых и располагаются молекулы антигена. Как антиген из макрофагов мозгового слоя передается в ретикулярные клетки коркового слоя, остается неизвестным.
К длинным отросткам ретикулярных клеток, содержащих антиген, подходят лимфоциты, а так как это происходит на границе тимусзависимых и тимуснезависимых областей, то естественно предположить, что распознавание антигена и кооперация Т- и В-клеток происходят именно в этих местах и что в ней участвуют дендритические клетки, репрезентирующие антиген, предварительно обработанный макрофагами. На периферии вторичных фолликулов, т. е. в непосредственном контакте с содержащими антиген ретикулярными клетками, происходит образование наиболее ранних в патогенетическом ряду клеток, синтезирующих антитела.

На 3-й день здесь обнаруживаются антителопродуцирующие плазмобласты, в которых синтезируются IgM-аптитела. Клональный характер развития этих клеток из родоначальных В-клеток предшественников твердо доказан. В случае тимусзависимых антигенов для начала пролиферации и дифференцировки этих клоногенных В-предшественников требуется их активация не только антигеном (через поверхностный рецептор в виде молекул встроенного в наружную клеточную мембрану иммуноглобулина), но и стимуляция со стороны активированной антигеном Т-клетки (Miller, 1974). Стимуляция осуществляется короткодистантным гуморальным фактором, который понижает порог чувствительности В-клетки к действию антигена.
Начавшая пролиферацию и дифференцировку В-клетка проделывает первые шесть мнтотических делений, находясь в корковом слое лимфоузла, затрачивая по 6—9 час на каждый митотический цикл. В результате образуется около 60 плазмобластов, продолжающих синтезировать IgM-аптитела сравнительно низкой авидности; интенсивность синтеза иммуноглобулинов в плазмобластах невелика. Следующие этапы своего развития потомки клоногенных клеток проделывают уже не в корковом, а в мозговом слое лимфоузлов.
Часть плазмобластов мигрирует при этом в мякотные шнуры и, продолжая размножаться на их территории, проделывает еще 2—4 деления, в результате которых образуется 250—1000 юных плазматических клеток, которые затем дифференцируются в уже неделящнеся зрелые плазматические клетки, срок жизни которых составляет около 48 час (Nossal, 1962). Синтез антител в юных, и особенно в зрелых плазматических клетках, происходит с гораздо большей интенсивностью, чем в плазмобластах, — около 107 молекул иммуноглобулина в час.
Иммунологическая специфичность этих секретируемых антител соответствует специфичности иммуноглобулиновых рецепторов, синтезируемых исходной В-клеткой (с интенсивностью 10 4 рецепторных молекул в час).
- Вернуться в оглавление раздела "Физиология человека."
X Международная студенческая научная конференция Студенческий научный форум - 2018

МОНОКЛОНАЛЬНЫЕ АНТИТЕЛА В ТЕРАПИИ ОНКОЛОГИЧЕСКИХ ЗАБОЛЕВАНИЙ
Текст работы размещён без изображений и формул.
Полная версия работы доступна во вкладке "Файлы работы" в формате PDF
В 1970-х годах молодой немецкий иммунолог Георг Кёлер изучал генетическую изменчивость антител. Для исследования надо было изолировать клон антителообразующих клеток (АОК) - плазматических клеток (производных от В-лимфоцитов). Необходимо отметить, что В-лимфоциты могут жить только в организме хозяина, и в искусственной питательной среде они быстро гибнут. Их длительное культивирование вне организма невозможно. Наоборот, клетки опухоли из плазматических клеток, называющиеся плазмоцитомами или миеломами, хорошо культивируются и размножаются in vitro и их называют “бессмертными».
Георг Кёлер Цезарь Мильштейн
Для реализации проекта Кёлер поехал в Англию, в лабораторию Цезаря Мильштейна, изучавшего клоны плазмоцитом, и они вместе разработали оригинальный подход к этой проблеме: решили получить гибрид нормальной антителообразующей клеткой (АОК) и опухолевой клетки. В случае успеха такой гибрид унаследовал бы от нормальной клетки способность к синтезу антител, а от опухолевой - бессмертие и способность к неограниченному и бесконтрольному росту. Это им удалось осуществить, создав гибридомную технологию.
Метод гибридизации соматических клеток in vitro осуществляется путем слияния разнородных клеток. Разнородные клетки, у которых слились оболочки, образовывали гибриды, которые сохраняли способность к клеточным делениям. Таким образом, возникал истинный гибрид, потомок двух соматических клеток, или гибридома. Кёлер и Мильштейн получили гибридому между нормальной АОК и опухолевой, миеломной клеткой.
Моноклональные антитела (МАТ) - это антитела лабораторного производства, связывающиеся с конкретными антигенами, например, с рецепторами раковых клеток, и при этом отсутствующие у нормальных клеток. Для создания МАТ мышам вводят раковые клетки человека, затем клетки селезенки, продуцирующие антитела, сливают с клетками мышиной миеломы, получая гибридную клетку – гибридому, которая путем деления производит идентичные дочерние клетки или клоны - отсюда термин «моноклональные». Антитела, секретируемые различными клонами, проверяются на способность узнавать свой антиген. С помощью этих бессмертных клеток гибридом могут быть получены большие количества антител. Поскольку антитела мыши могут сами вызывать иммунный ответ у людей, в мышиных антителах часто заменяют большую часть мышиного антитела на человеческие [1,3,4].
Для получения больших объемов жидкости, содержащей моноклональные антитела, гибридомы могут быть введены внутрибрюшинно мышам реципиентам. В результате в брюшной полости вырастает солидная опухоль и накапливается асцитическая жидкость, являющаяся источником моноклональных антител. Полученные клоны можно заморозить при -70 0 С и длительно сохранять. Их можно культивировать и накапливать антитела в культуральной среде, а можно привить мышам, где они будут расти и накапливать колоссальные количества моноклональных антител. От одной мышки можно получить антител не меньше, чем от кролика. Эти антитела не содержат посторонних антител и настолько однородны, что могут рассматриваться как чистые химические реагенты.
Таким образом, клоны-продуценты моноклональных антител (гибридомы) получают слиянием антителообразующих клеток лимфоидной ткани иммунизированного животного и клеток плазмацитомы. Полученные в результате клетки наследуют от лимфоцитов способность к секреции антител и от клеток миеломы способность к неограниченному росту in vitro [5].
В терапии опухолей используют два типа МАТ: простые (не связанные ни с какими цитотоксическими веществами) и конъюгированные- МАТ, лечебный эффект которых обусловлен присоединенными к антителу веществами (радиоактивными частицами, цитостатиками или токсинами). Механизм терапевтического действия антител можно рассмотреть на примере алемтузумаба – МАТ против антигена лимфоцитов CD52, обладающих противоопухолевым и иммуносупрессивным действием, направленного на лечение хронического лимфолейкоза и кожной Т-клеточной лимфомы. Вариабельный регион алемтузумаба соединяется с антигеном CD52 на поверхности лимфоцитов, а константный регион - с Fc-рецепторами на поверхности цитотоксических клеток, которые уничтожают мишень. Кроме того, препарат активирует систему комплемента, что приводит к образованию комплекса, разрушающего мембрану злокачественной клетки. Именно эти два механизма, а также индукция апоптоза считаются основными в действии МАТ. Характер иммунотерапии зависит от разновидности опухоли. Так, при раке легкого используется авастин - гуманизированное рекомбинантное гиперхимерное моноклональное антитело, которое селективно связывается с биологически активным фактором роста эндотелия сосудов, нейтрализуя его [2].
Действие mAb на клетку опухоли.
1 — антитело mAb связывается с антигеном опухолевой клетки и вызывает или ее комплемент-зависимую гибель, или гибель в результате антителозависимой атаки макрофагами.
2 — с mAb связан радиоактивный изотоп, токсин или цитокин, вызывающие гибель клетки. Также с антителами может быть связан фермент, участвующий в превращении препарата в активную форму.
3 — биспецифические mAb. Один сайт связывается с опухолевой клеткой, другой — с киллерной эффекторной клеткой.
4 — антитела mAb связаны с липосомами, которые содержат химотерапевтические препараты или токсины.[6]
Разработка новых моноклональных антител и совершенствование схем терапии злокачественных опухолей с их помощью является одним из наиболее перспективных направлений в онкологии, дающих больше шансов на продление активных лет жизни онкологическим больным.
1.Ефетов К.А., Тэтин С.Ю., Князева О.А. Штамм гибридных культивируемых клеток животных Mus musculus L., используемый для получения моноклональных антител к IgG человека. Патент на изобретение RUS 2008350.
3.Князева О.А., Ефетов К.А., Тэтин С.Ю., Троицкий Г.В. Штамм гибридных культивируемых клеток Mus musculus L.,используемый для получения преципитирующих моноклональных антител к IgG человека. Патент на изобретение RUS 2010856.
4.Князева О.А., Камилов Ф.Х. Комплемент и антитела при онкологических заболеваниях. Результаты исследований. Германия: LAP LAMBERT Academic Publishing, 2011. – 284 c.
5- Моноклональные антитела. Использование в диагностике заболеваний и лечебные моноклональные антитела.: Методические рекомендации для студентов лечебного, педиатрического, стоматологического и фармацевтического факультетов. / Ю.И.Будчанов. - Тверь. 2012г.- 22 с.
XI Международная студенческая научная конференция Студенческий научный форум - 2019
В 1970-х годах Цезарь Мильштейн и Георг Кёлер получили гибрид нормальной антителообразующей клетки (АОК) с опухолевой, используя разработанную ими методику получения моноклональных антител (МАТ), за которую в 1984 г. они были удостоены Нобелевской премии.
Для получения МАТ используют взвесь клеток (с большим содержанием В-лимфоцитов), полученных из селезенки иммунизированной мыши. При слиянии их с опухолевой клеткой образуются гибридные клетки - гибридомы [1]. Отбор продуктивных гибридных клеток проводится при длительной
инкубации первичной культуры в среде, содержащей гипоксантин, аденозин и тимидин – ГАТ-среде. Клетки селезенки могут преодолевать действие ингибитора, используя для синтеза ДНК гипоксантин и тимидин. В результате получают гибридому, продуцирующую моноклональные антитела. Производство моноклональных антител этими клетками осуществляют in vitro в биореакторе или in vivo в асцитной жидкости мыши. (рис.1)
Рис. 1. Схема получения МАТ.
А, В, С - многокомпонентная смесь антигенов, использованная для иммунизации (или сложные антигены с множеством антигенных детерминант);
АОК - антителообразующие клетки селезенки;
Пл - клетки плазмоцитомы, не растущие в селективной ГАТ- среде;
ГАТ - среда, содержащая гипоксантин, аминоптерин, тимидин; анти-А, анти-В, анти-С - моноклональные антитела соответственно к А-, В-, С-антигенам (или антигенным детерминантам).
В терапии онкологических заболеваний используются как неконъюгированные МАТ, не связанные с цитотоксическими веществами, так и конъюгированные, лечебный эффект которых обусловлен присоединенными к ним веществами (радиоактивными частицами, цитостатиками или токсинами). Большинство из них связывается с антигенами опухолевых клеток, но при этом они зачастую могут взаимодействовать с антигенами на здоровых клетках, а также другими свободными белковыми рецепторами [6].
Большинство из применяемых в онкологии МАТ-неконъюгированные, которые в различной степени реализуют свое воздействие на злокачественную опухоль. Одни антитела, связываясь с соответствующим антигеном, запускают естественные механизмы иммунного ответа организма и разрушают опухолевые клетки. Другие - не взаимодействуют с иммунной системой человека. Их эффект реализуется через связывание с антигенами, обеспечивая пролиферацию клеток или рост опухоли [5, 6].
Важно отметить, что полученный с помощью гибридомы клеточный клон является мышиным иммуноглобулином, который при попадании в организм человека вызовет реакцию отторжения. Однако благодаря рекомбинантным технологиям, взяв фрагмент мышиного моноклона и соединив его с фрагментом человеческого иммуноглобулина, были получены гибридомы, получившие название химерных
Первые МАТ, одобренные для применения в терапии онкологических заболеваний, это ритуксимаб (ритуксан, мабтера), представляющий собой химерные моноклональные антитела мыши / человека специфически связывающиеся с антигеном CD 20+ (рис. 2).
Рис. 2. Химерные моноклональные антитела мыши / человека.
Данный антиген локализуется на поверхности В-лимфоцитов, но отсутствует на стволовых гемопоэтических клетках и здоровых клетках других тканей. Другие гуманизированные МАТ, связывающееся с антигеном CD 52 –алемтузумаб (кампат, кэмпас). Эти антигены экспрессируются на мембране большинства опухолевых T - и В- лимфоцитов с очень высокой плотностью [6].
Перспективным направлением в создании новых препаратов на основе моноклональных антител, является использование каталитических антител - абзимов. Эти молекулы обладают свойствами антител, т.к. могут связываться с определенными эпитопами, и в то же время они являются биокатализаторами биохимических реакций, участвуя в опухолевой инвазии и метастазировании [5].
Список литературы:
1. Будчанов Ю.И. Моноклональные антитела. Использование в диагностике заболеваний и лечебные моноклональные антитела. Тверь. 2012г.,С.5-9.
2. Патент на изобретение RUS 2003680. Штамм гибридных культивируемых клеток mus muscukus l ., используемый для получения преципитирующих моноклональных антител к IgM человека / Ефетов К.А., Тэтин С.Ю., Князева О.А., Троицкий Г.В. –Опубл. 10.01.1992.
3. Ефетов К.А., Князева О.А. Применение моноклональных антител к иммуноглобулинам человека в реакции иммунопреципитации // Иммунология. - 1994. - Т. 15, № 3. - С. 57-58.
4.Княз e в a , O . A . Вз a им o д e й c тви e к o мпл e м e нт a c имм y н o гл o б y лин a ми G и к o нф op м a ци o нны e изм e н e ния к o мп o н e нт a C 3 п p и н eo пл ac тич ec ких п po ц ecca х: дис. . д-ра биол. наук: 03.00.04, 03.00.02 / Княз e в a O льг a A л e к ca нд po вн a . – Уфа, 2008. – 288 c .
5. Князева О.А., Камилов Ф.Х. Комплемент и антитела при онкологических заболеваниях. Результаты исследований. Германия: LAP LAMBERT Academic Publishing , 2011. – 284 c .
6. Кеннет Р. Г., Мак-Керн Т. Дж., Бехтол К. Б. Моноклональные антитела: Гибридомы: новый уровень биологического анализа. М.: Медицина, 1983. – 169 с
Читайте также:
